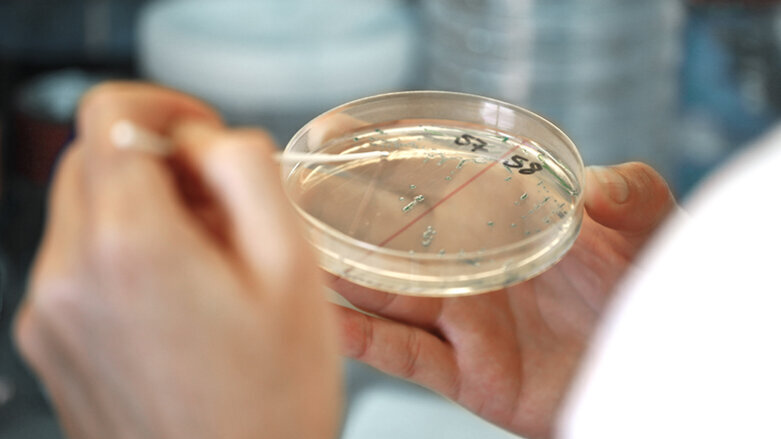
UZH: Antibiotika mit neuartiger Wirkung entdeckt

ZÜRICH – Viele lebensbedrohliche Bakterien werden zunehmend resistent gegen Antibiotika. Forschende der Universität Zürich und der Polyphor AG haben eine neue Antibiotikaklasse entdeckt, die gegen mehrere Bakterien wirksam ist und über einen einzigartigen Wirkmechanismus verfügt. Sie blockiert den Aufbau der äusseren Membran und tötet so gramnegative Bakterien effektiv ab.
Die rasche Verbreitung von Antibiotikaresistenzen ist ein weltweites Problem. Nach Angaben der Weltgesundheitsorganisation (WHO) stellen insbesondere gramnegative Bakterien, die gegen Carbapenem- und Cephalosporin-Antibiotika resistent sind, eine wachsende Bedrohung für die menschliche Gesundheit dar. Diese Erreger können schwere und oft lebensbedrohliche Infektionen wie Lungen- oder Hirnhautentzündungen, Wundinfekte oder Blutvergiftungen verursachen. Die letzte neue Klasse von Antibiotika, die gegen diese Mikroorganismen auf den Markt kam – die Fluorchinolone – stammt aus den 1960er-Jahren. Neue Antibiotika mit neuartigen Wirkmechanismen gegen gramnegative Bakterien werden dringend benötigt, zumal auch Resistenzen gegen das letzte Reserve-Antibiotikum Colistin weltweit zunehmen.
Neuartige Antibiotika gegen gefährliche Bakterien
Schweizer Forscherteams unter der gemeinsamen Leitung der Universität Zürich (UZH) und der Polyphor AG haben eine neue Familie von synthetischen Antibiotika, die gegen diverse gramnegative Mikroben wirken, entdeckt und charakterisiert. «Die neuen Antibiotika interagieren mit Proteinen der Aussenmembran von gramnegativen Bakterien», sagt John Robinson vom Institut für Chemie der UZH, einer der Co-Leiter der Studie. «Nach unseren Ergebnissen binden die Antibiotika einerseits an fettähnliche Membrankomponenten, den sogenannten Lipopolysacchariden, und andererseits an das Membranprotein BamA, das für den Aufbau der äusseren Hülle von gramnegativen Bakterien essenziell ist», ergänzt Robinson.
Aufbau der äusseren Membran wird blockiert
BamA ist der Hauptbestandteil des sogenannten ß-Faltkomplexes (BAM), der für die Synthese der Aussenmembran unerlässlich ist. Nachdem die Antibiotika an dieses Protein binden, wird die Bakterienmembran zerstört, und die Zellen platzen. Die Aussenmembran schützt Bakterien etwa vor toxischen Umweltfaktoren und Antibiotika. Zudem ist sie für die Aufnahme und den Export von Nährstoffen und Signalmolekülen verantwortlich. «Trotz ihrer Bedeutung zielen keine der bisher klinisch eingesetzten Antibiotika auf Schlüsselproteine, die für die Biogenese der Aussenmembran erforderlich sind», sagt Robinson.
Klinische Phase I-Studie in Planung
Das Forschungsprojekt wurde in enger Zusammenarbeit mit der Polyphor AG durchgeführt, einem ehemaligen UZH-Start-up-Unternehmen, das 1996 gegründet wurde. Das biopharmazeutische Unternehmen mit Sitz in Allschwil plant nun, eine der Substanzen in die klinische Prüfung am Menschen zu bringen. «POL7306, ein erstes Leitmolekül der neuartigen Antibiotika-Klasse, befindet sich derzeit in der präklinischen Entwicklung», sagt Daniel Obrecht, Chief Scientific Officer bei Polyphor und Co-Studienleiter.
Literatur:
Anatol Luther et. al. Chimeric Peptidomimetic Antibiotics Against Gram-Negative Bacteria. Nature. 23 October 2019. DOI: 10.1038/s41586-019-1665-6
Schlagwörter:
ZÜRICH - Krankheiten und Verletzungen lösen in den Zellen unseres Körpers Warnsignale aus. Dadurch werden Gene abgeschrieben und Eiweisse neu...
HALLE/SAALE - Neuartige bioabbaubare Stäbchen versprechen eine besser verträgliche Behandlung von Parodontitis.
LEIPZIG - Mit dem Ultraschallgerät CaviTAU ist es gelungen, den bestrahlungsfreien Ultraschall auch in der Zahnmedizin anzuwenden. Im Rahmen eines ...
BASEL – Seit Anfang des Jahres gibt es in Basel am UZB eine neue Anlaufstelle für Speicheldiagnostik und Mundtrockenheit. Unter der Leitung von ...
ZÜRICH - Bis ins Jahr 2020 will die Universität Zürich anteilmässig deutlich mehr Masterstudierende und Doktorierende ausbilden. Zudem ...
Nottingham – Der natürliche Zahnschmelz ist das härteste biologische Material im menschlichen Körper. Trotz seiner geringen Dicke von nur wenigen ...
Bern – Die Versorgung mit Antibiotika und Impfstoffen in der Humanmedizin hat sich in der Schweiz stabilisiert. Die schwere Mangellage ist behoben, ...
Basel – Das UZB Universitäres Zentrum für Zahnmedizin Basel feiert im Jahr 2024 seinen 100. Geburtstag. Dieser Anlass wurde am 1. Juni mit dem ...
LE CHÊNE, FRANKREICH – Ein Fund aus Frankreich lässt vermuten, dass die Zahnästhetik bereits vor 2.300 Jahren eine ...
BASEL - Bei der Verteilung von Krebszellen im Körper und der Metastasenbildung spielt ein bestimmter Gen-Hauptschalter eine zentrale Rolle: Ein ...
Live-Webinar
Di. 23. Juni 2026
2:00 Uhr (CET) Zurich
Live-Webinar
Di. 23. Juni 2026
19:00 Uhr (CET) Zurich
Live-Webinar
Di. 23. Juni 2026
21:00 Uhr (CET) Zurich
Live-Webinar
Mi. 24. Juni 2026
14:00 Uhr (CET) Zurich
Live-Webinar
Mi. 24. Juni 2026
17:00 Uhr (CET) Zurich
Live-Webinar
Mi. 24. Juni 2026
18:30 Uhr (CET) Zurich
Dr. med. dent. Britta Hahn
Live-Webinar
Do. 25. Juni 2026
20:00 Uhr (CET) Zurich
Dr. Hatem Algraffee, Cat Edney



 Österreich / Österreich
Österreich / Österreich
 Bosnien und Herzegowina / Босна и Херцеговина
Bosnien und Herzegowina / Босна и Херцеговина
 Bulgarien / България
Bulgarien / България
 Kroatien / Hrvatska
Kroatien / Hrvatska
 Tschechien & Slowakei / Česká republika & Slovensko
Tschechien & Slowakei / Česká republika & Slovensko
 Frankreich / France
Frankreich / France
 Deutschland / Deutschland
Deutschland / Deutschland
 Griechenland / ΕΛΛΑΔΑ
Griechenland / ΕΛΛΑΔΑ
 Ungarn / Hungary
Ungarn / Hungary
 Italien / Italia
Italien / Italia
 Niederlande / Nederland
Niederlande / Nederland
 Nordic / Nordic
Nordic / Nordic
 Polen / Polska
Polen / Polska
 Portugal / Portugal
Portugal / Portugal
 Rumänien & Moldawien / România & Moldova
Rumänien & Moldawien / România & Moldova
 Slowenien / Slovenija
Slowenien / Slovenija
 Serbien & Montenegro / Србија и Црна Гора
Serbien & Montenegro / Србија и Црна Гора
 Spanien / España
Spanien / España
 Schweiz / Schweiz
Schweiz / Schweiz
 Türkei / Türkiye
Türkei / Türkiye
 Großbritannien und Irland / UK & Ireland
Großbritannien und Irland / UK & Ireland
 International / International
International / International
 Brasilien / Brasil
Brasilien / Brasil
 Kanada / Canada
Kanada / Canada
 Lateinamerika / Latinoamérica
Lateinamerika / Latinoamérica
 USA / USA
USA / USA
 China / 中国
China / 中国
 Indien / भारत गणराज्य
Indien / भारत गणराज्य
 Pakistan / Pākistān
Pakistan / Pākistān
 Vietnam / Việt Nam
Vietnam / Việt Nam
 ASEAN / ASEAN
ASEAN / ASEAN
 Israel / מְדִינַת יִשְׂרָאֵל
Israel / מְדִינַת יִשְׂרָאֵל
 Algerien, Marokko und Tunesien / الجزائر والمغرب وتونس
Algerien, Marokko und Tunesien / الجزائر والمغرب وتونس
 Naher Osten / Middle East
Naher Osten / Middle East